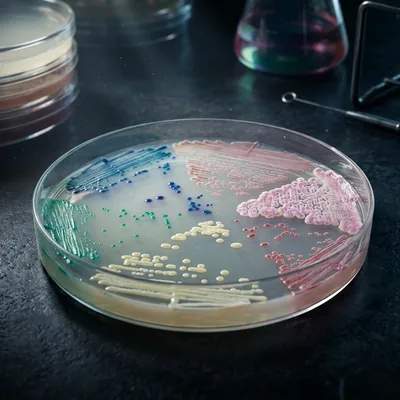
Medios Cromogénicos

Catálogo Operativo
Explora productos y servicios para alimentos
3,237 Productos
Todo lo que prende, mide, calienta, gira o cuenta.


pH-metros
1 producto
Incubadoras y Baños
32 productos
Equipo para determinación de cloro
1 producto
Autoclaves y Esterilizadores
37 productos
Luminómetros
1 producto
Cabinas de Seguridad Biológica
11 productos
Manejo y Transferencia
5 productos
Lectores ELISA
1 producto
Análisis Microbiológico Automatizado
3 productos
Equipos de Calentamiento y Agitación
21 productos
Muestreo
1 producto
Lectores de micotoxinas
1 producto
Refrigeración de Laboratorio
13 productos
Visualización UV
5 productos
Repuestos UV
2 productos
Centrífugas
10 productos
Equipos Automatizados de Agua
1 producto
Microscopios
2 categorías
Contadores de Colonias
8 productosTodo lo que se gasta o se repone en la operación diaria.

Medios de cultivo
518 productos
Bolsas Estériles - Muestreo
69 productos
Estériles y Control
147 productos
CompactDry
1 producto
Medios Cromogénicos
17 productos
Recipientes
42 productos
Soluciones para patógenos
73 productos
Cepas Microbiológicas
103 productos
Soluciones para micotoxinas
83 productos
Suplementos y Aditivos
20 productos
Soluciones para alérgenos
27 productos
Material de Laboratorio
1 producto
Soluciones para análisis de agua
100 productos
Soluciones para antibióticos en leche
26 productos
Análisis Microbiológico de Agua
281 productos
Análisis Fisicoquímico
49 productos
Reactivos Químicos
33 productos
Consumibles de laboratorio
5 productos
Análisis de Pesticidas
5 productos
Serología Aviar
88 productos
Kit de Diagnóstico de Enfermedades
13 productos
Serología Porcina
19 productos
Patógenos Alimentarios
44 productos
Tests Confirmatorios
34 productosLo que no es reactivo ni equipo, pero se usa cada día.

Labware General
843 productos
Cristalería y Material de Vidrio
76 productos
Seguridad y Protección
14 productos
Termómetros de Laboratorio
50 productos
Detectables (industria alimentaria)
5 productos
Plásticos y Desechables
51 productos
Papelería Técnica
22 productos
Herramientas de Laboratorio
16 productos
Almacenamiento y Organización
30 productosSoporte especializado para equipos críticos.
Productos destacados
Mostrando 2 productos
Cobertura Regional
Soporte en 5 paises
Contacta al especialista de tu zona para pedidos, cotizaciones y soporte tecnico. Nuestro equipo esta listo para ayudarte.
🇬🇹
Ver mapa regionalGuatemalaguatemala@agrobiotek.com
🇸🇻El Salvadorelsalvador@agrobiotek.com
🇭🇳Hondurashonduras@agrobiotek.com
🇳🇮Nicaraguanicaragua@agrobiotek.com
🇩🇴República Dominicanaventasdominicana@agrobiotek.com


